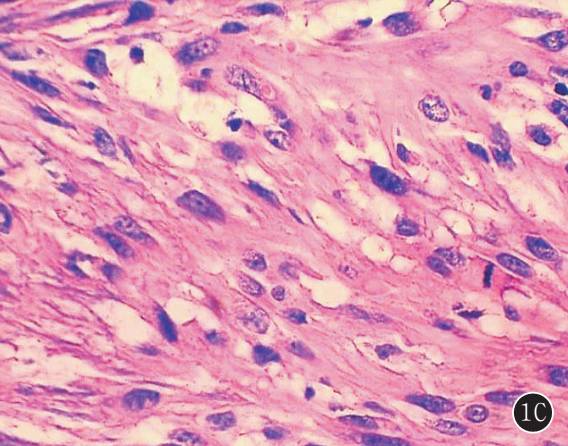
原发性肺肉瘤的CT诊断及鉴别诊断

原发性肺肉瘤的CT诊断及鉴别诊断
发布时间:2022-10-21
发布时间:2022-10-21

图 2A,B 右下肺纤维肉瘤。 A. 肿块密度不均匀,边缘见分叶征,局部与邻近胸膜关系密切;B. 肿瘤由单一的异型梭形细胞组成,细胞呈较规则的束状排列(HE ×100)
图 3A,B 右上肺滑膜肉瘤。 A. 增强后肿块边缘可见强化的包膜,内部见低密度坏死区,肿块与邻近的胸膜组织粘连,伴右侧胸腔积液;B. 梭形细胞相对较小,细胞密度较高,较一致,核染色细腻(HE ×100)
图 4A,B 左肺未分化多形性肉瘤(中央型)。 A. 左主支气管腔内可见软组织肿块影,左肺完全不张;B. 肿瘤由大量异型明显梭形细胞组成,核大深染(HE ×100)

![]()
下一篇:乳腺单纯型黏液腺癌的MRI表现